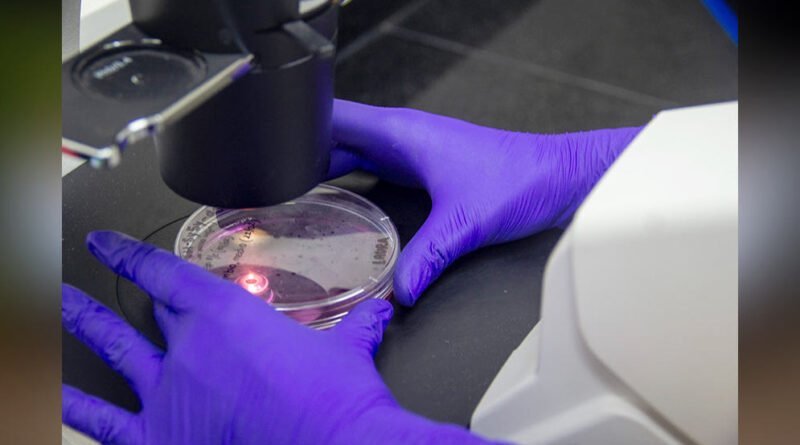

El CONICET y un alentador avance contra el Parkinson
Un equipo de investigadores del CONICET, la Universidad Nacional de Tucumán (UNT) y la Universidad de Buenos Aires (UBA), en colaboración con la empresa biotecnológica norteamericana Sky Bio LLC, ha logrado un importante avance en el tratamiento de la enfermedad de Parkinson. Mediante ensayos preclínicos, han desarrollado una nueva molécula que no solo mejora los síntomas característicos de esta afección, sino que también muestra una destacada actividad neuroprotectora. Este descubrimiento promete ofrecer nuevas esperanzas a millones de personas que padecen esta enfermedad neurodegenerativa.
La molécula, denominada Pegasus o DAD 9, ha sido patentada tanto en los Estados Unidos como en la Unión Europea, y el trabajo de investigación ha sido aceptado para su publicación en una prestigiosa revista científica. Pegasus se distingue por ser la primera molécula capaz de abordar los dos principales problemas asociados con la enfermedad de Parkinson: la mejora de los síntomas y la prevención de la progresión de los daños neuronales. Este compuesto, considerado un candidato a fármaco, ha superado con éxito la etapa preclínica y se encuentra próximo a iniciar las pruebas clínicas en humanos tras obtener la autorización de la Food and Drug Administration (FDA).
El equipo de investigación, liderado por la doctora Rosana Chehín, investigadora del CONICET y docente de la UNT, ha trabajado arduamente en este proyecto durante la última década. La colaboración entre expertos en neurociencia y química sintética ha sido fundamental para el desarrollo de esta innovadora molécula. El compuesto actúa como un agonista dopaminérgico, similar a la dopamina, neurotransmisor esencial en el cerebro, y presenta una actividad neuroprotectora al prevenir la formación de especies tóxicas de la proteína alfa-sinucleina, asociada con la enfermedad de Parkinson.
Según explica la Dra. Chehín, Pegasus representa una esperanza para los pacientes de Parkinson, ofreciendo una alternativa potencialmente más efectiva y segura que los tratamientos convencionales. La molécula fue diseñada para transportar dopamina al cerebro, aprovechando el sistema de transporte de las tetraciclinas, y conserva las mejores propiedades de la dopamina y la tetraciclina, sin los efectos adversos asociados con esta última a largo plazo.
El desarrollo de Pegasus es el resultado de la colaboración entre el sector público y el privado, con el aporte económico de Sky Bio LLC, empresa biotecnológica fundada por el empresario Claude Burgio. La integración entre distintos grupos científicos y la contribución de entidades públicas y privadas han sido clave para alcanzar este importante logro.
Durante la presentación del trabajo, el presidente del CONICET, Daniel Salamone, felicitó al equipo de investigación y destacó la importancia de la colaboración entre científicos y empresas para promover el desarrollo de soluciones innovadoras. Por su parte, Oscar Varela, especialista del CIHIDECAR (CONICET-UBA) y uno de los referentes del proyecto, expresó su satisfacción por haber arribado a esta patente, resaltando la capacidad de los argentinos para enfrentar desafíos científicos y tecnológicos.
El rector de la UNT, José Pagani, y el ministro de Salud de Tucumán, Luis Medina Ruiz, también celebraron este importante avance, destacando el valor de la investigación básica y la colaboración interdisciplinaria en la búsqueda de soluciones para enfermedades devastadoras como el Parkinson.
En última instancia, Claude Burgio, fundador y presidente de Sky Bio LLC, reconoció el esfuerzo conjunto de los equipos de investigación y destacó este proyecto como un excelente modelo de cooperación entre el sector público y privado. El desarrollo de Pegasus representa un hito en la lucha contra el Parkinson y ofrece nuevas perspectivas para mejorar la calidad de vida de los pacientes afectados por esta enfermedad.